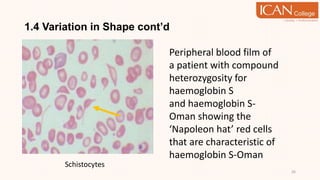
1.4 Variation in Shape cont’d
26
Schistocytes
Peripheral blood film of
a patient with compound
heterozygosity for
haemoglobin S
and haemoglobin S-
Oman showing the
‘Napoleon hat’ red cells
that are characteristic of
haemoglobin S-Oman
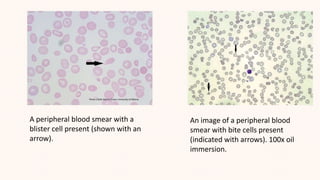
An image of a peripheral blood
smear with bite cells present
(indicated with arrows). 100x oil
immersion.
A peripheral blood smear with a
blister cell present (shown with an
arrow).
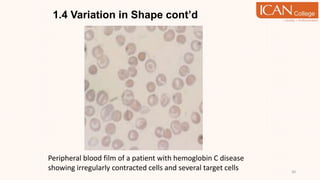
1.4 Variation in Shape cont’d
30
Peripheral blood film of a patient with hemoglobin C disease
showing irregularly contracted cells and several target cells
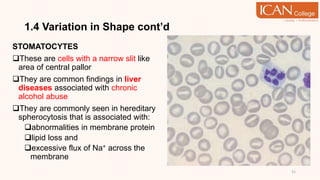
1.4 Variation in Shape cont’d
STOMATOCYTES
These are cells with a narrow slit like
area of central pallor
They are common findings in liver
diseases associated with chronic
alcohol abuse
They are commonly seen in hereditary
spherocytosis that is associated with:
abnormalities in membrane protein
lipid loss and
excessive flux of Na+ across the
membrane
31
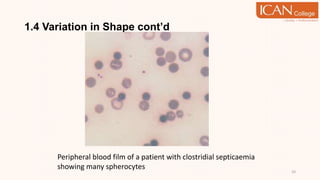
1.4 Variation in Shape cont’d
33
Peripheral blood film of a patient with clostridial septicaemia
showing many spherocytes
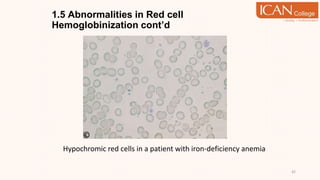
1.5 Abnormalities in Red cell
Hemoglobinization cont’d
42
Hypochromic red cells in a patient with iron-deficiency anemia
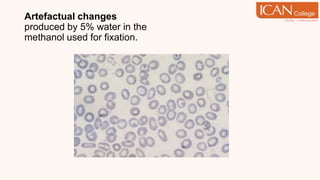
Artefactual changes
produced by 5% water in the
methanol used for fixation.
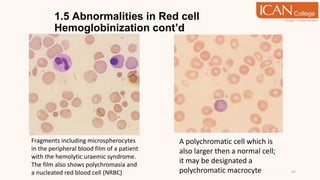
1.5 Abnormalities in Red cell
Hemoglobinization cont’d
47
Fragments including microspherocytes
in the peripheral blood film of a patient
with the hemolytic uraemic syndrome.
The film also shows polychromasia and
a nucleated red blood cell (NRBC)
A polychromatic cell which is
also larger then a normal cell;
it may be designated a
polychromatic macrocyte
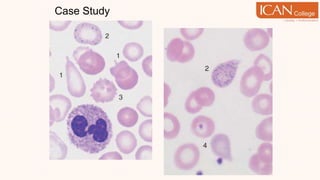
Case Study
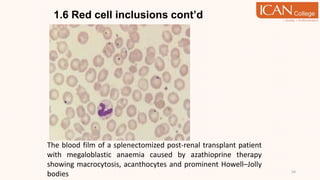
1.6 Red cell inclusions cont’d
54
The blood film of a splenectomized post-renal transplant patient
with megaloblastic anaemia caused by azathioprine therapy
showing macrocytosis, acanthocytes and prominent Howell–Jolly
bodies
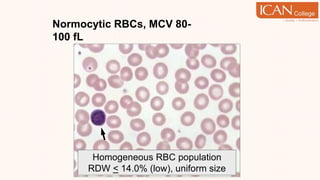
Normocytic RBCs, MCV 80-
100 fL
Homogeneous RBC population
RDW < 14.0% (low), uniform size
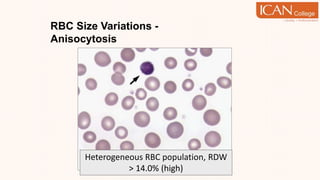
RBC Size Variations -
Anisocytosis
Heterogeneous RBC population, RDW
> 14.0% (high)
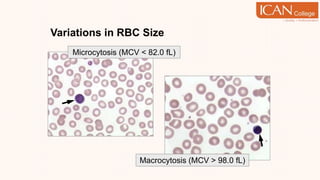
Variations in RBC Size
Microcytosis (MCV < 82.0 fL)
Macrocytosis (MCV > 98.0 fL)
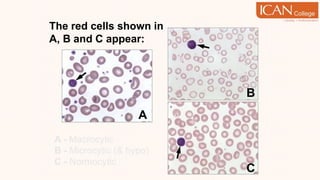
The red cells shown in
A, B and C appear:
A - Macrocytic
B - Microcytic (& hypo)
C - Normocytic
A
B
C
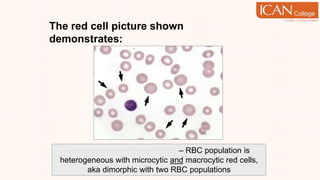
The red cell picture shown
demonstrates:
Anisocytosis with high RDW – RBC population is
heterogeneous with microcytic and macrocytic red cells,
aka dimorphic with two RBC populations
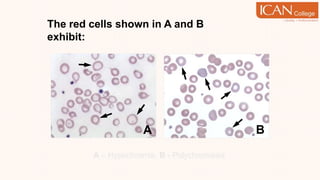
The red cells shown in A and B
exhibit:
A – Hypochromia, B - Polychromasia
B
A
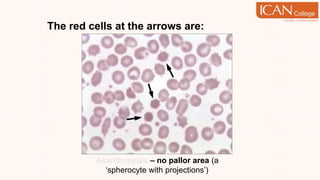
The red cells at the arrows are:
Acanthocytes – no pallor area (a
‘spherocyte with projections’)
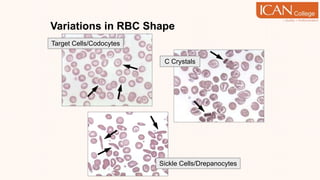
Variations in RBC Shape
Target Cells/Codocytes
C Crystals
Sickle Cells/Drepanocytes
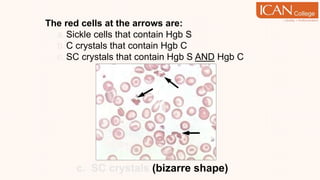
The red cells at the arrows are:
a.Sickle cells that contain Hgb S
b.C crystals that contain Hgb C
c. SC crystals that contain Hgb S AND Hgb C
c. SC crystals (bizarre shape)
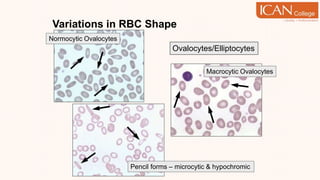
Variations in RBC Shape
Pencil forms – microcytic & hypochromic
Ovalocytes/Elliptocytes
Normocytic Ovalocytes
Macrocytic Ovalocytes
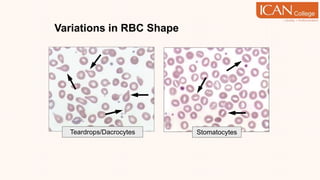
Variations in RBC Shape
Stomatocytes
Teardrops/Dacrocytes
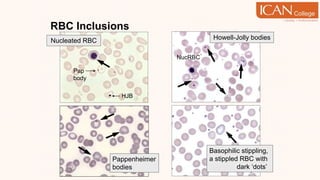
RBC Inclusions
Basophilic stippling,
a stippled RBC with
punctate dark ‘dots’
Howell-Jolly bodies
Pappenheimer
bodies
NucRBC
Nucleated RBC
HJB
Pap
body
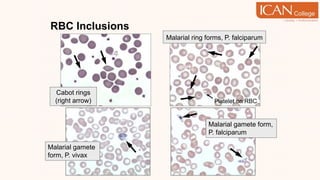
RBC Inclusions
Malarial gamete
form, P. vivax
Malarial gamete form,
P. falciparum
Malarial ring forms, P. falciparum
Platelet on RBC
Cabot rings
(right arrow)
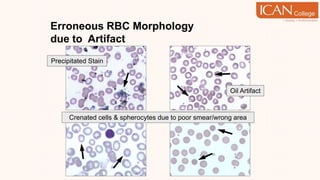
Erroneous RBC Morphology
due to Artifact
Oil Artifact
Precipitated Stain
Crenated cells & spherocytes due to poor smear/wrong area

The document provides an in-depth study of red cell morphology, emphasizing the assessment of both normal and abnormal erythrocyte forms using stained blood films. It discusses various morphological features such as variations in size, shape, color, and specific inclusions in red blood cells, as well as their relevance in diagnosing hematologic disorders. Additionally, it covers abnormalities in red cell hemoglobinization and the grading system used for evaluating changes in erythrocyte morphology.